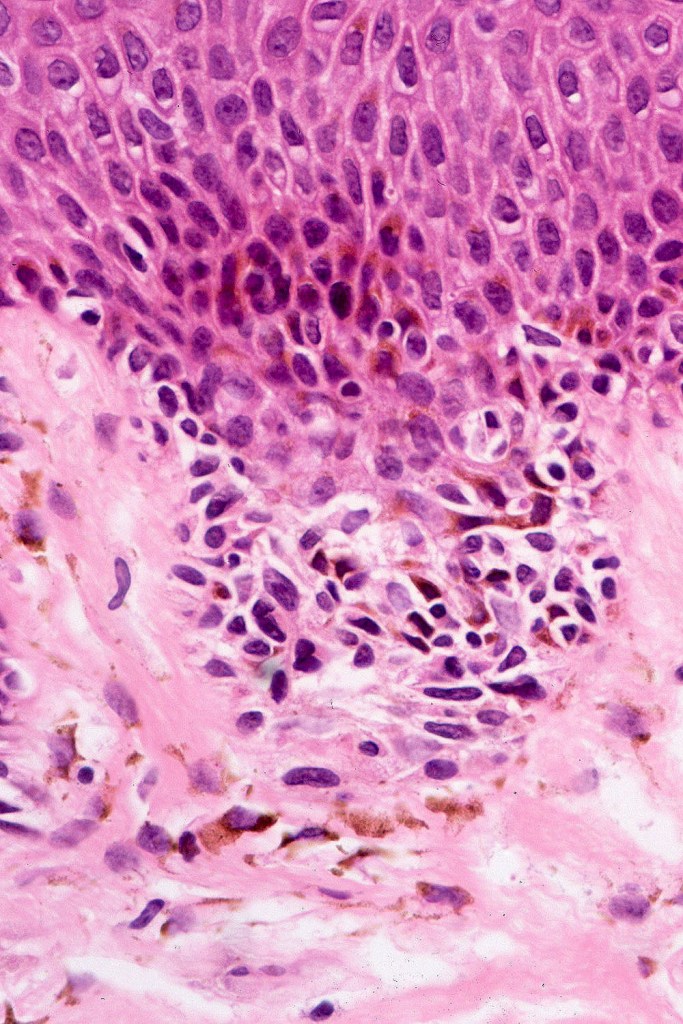

Dysplastic nevi can be sporadic (much more common) or multiple. In patients with dysplastic nevus syndrome (Familial Atypical Multiple Mole Melanoma syndrome) dysplastic nevi may number in hundreds. Patients with this syndrome are at a great risk of developing melanoma (de novo much more often than complicating a dysplastic nevus)
Clinical features

•Sporadic>>familial
•10% of population (range 7- 24% in general population)
•Become apparent after puberty and can present in the older age groups
•Sun-exposed and non sun-exposed including scalp, breast & buttocks
•More common in Fitzpatrick type I & II skin
•1-100’s
•>5mm diameter
•Irregular borders
•Irregular pigmentation
•Shoulder when compound
•Significant factor for developing melanoma
•The greater the number of dysplastic nevi the greater is the risk
•Dysplastic nevus syndrome/Familial atypical multiple mole melanoma syndrome patients are at great risk of developing melanoma




Histological features
•Architectural disorder- lentiginous and nested, nests abnormally located (at the sides of the rete ridges & overlying the dermal papillae in addition to the tips of the rete ridges rather than solely occupying the tips of the rete ridges as is seen in banal nevi), horizontal orientation & bridging between junctional nests (this should not be confused with bridging between adjacent rete ridge squamous epithelium)
•Abnormal fine pigmentation (dusty)
•Cytological atypia- mild, moderate & severe (or more recently, low & high grade (WHO). The problem with the new WHO classification is that mildly dysplastic nevi are now included with the banal nevus category and moderate is low grade and severe is high grade. In all likelyhood, most pathologists will include mild & moderate atypia in the low grade category.
•Variation in the degree of atypia within any one lesion is commonly present
•Rare mitoses
•Pagetoid spread absent
•Host response- eosinophilic & lamellar fibroplasia, increased vascularity, lymphocytic infiltration & pigment incontinence
•In compound lesions, the nest size should be smaller than the junctional ones and the degree of atypia the same or less
•No dermal mitoses

Immunohistochemiatry & molecular data
•IHC is of no value in purely junctional lesions with the possible exception of PRAME
•Ki67 & Cyclin D1 should reveal no significant expression in the dermal component & PRAME should be negative
•Not generally associated with mutations in major melanoma susceptibility genes CDKN2A & CDK4
•Mutations in BRAF-V600E, p53 & p16
•Up to 20% of melanomas (superficial spreading) arise in dysplastic nevi?? Not my experience
•MicroRNAs suggest that dysplastic nevi are distinct from melanoma
Differential diagnosis
Dysplastic nevus in the majority of cases is instantly recognizable, often at low power. The most important differential diagnosis is obviously melanoma. In junctional lesions, widespread/uniform high grade atypia, frequent mitoses and Pagetoid spread are indicative of in situ melanoma. In compound lesions, dermal nests larger than junctional ones, expansile dermal nests, severe atypia and mitotic activity indicate the presence of melanoma
Dysplastic nevus is sometimes confused with early/evolving Reed nevi. The presence of an almost pure population of uniform, spindled melanocytes, often heavily pigmented nested lesion forming a flattened lower border make the distinction fairly straightforward. Reed nevus is symmetrical & circumscribed.
Dysplastic nevus with early melanoma







Leave a comment